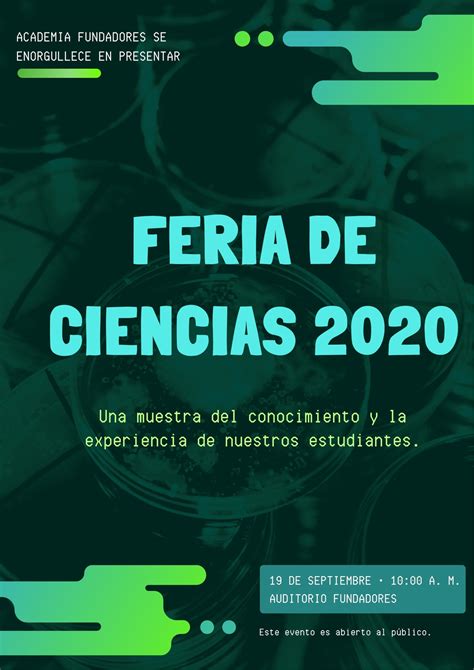
Ejemplo de un póster de feria de ciencias con texto personalizado y paleta de colores vibrante.

Despierta la curiosidad y exhibe tu brillantez científica con las cautivadoras plantillas de pósteres para ferias de ciencias. Desde coloridas infografías hasta atractivos elementos visuales, nuestras plantillas te ayudan a comunicar conceptos complejos de forma clara y visualmente atractiva. Tanto si realizas experimentos como si compartes descubrimientos revolucionarios, deja que estas plantillas eleven tu presentación e inspiren curiosidad en la mente de tu público.

La Feria de Ciencias: Un Momento Clave en el Año Escolar
Cada año escolar, los estudiantes esperan con ansias la feria de ciencias. Es el momento en que pueden mostrar sus experimentos, sus creaciones científicas e ideas innovadoras. Los padres también están impacientes por ver lo que sus hijos aprendieron en la escuela y esperan ser sorprendidos por el ingenio de la siguiente generación.
Crea un Cartel Impactante para tu Feria de Ciencias
Genera aún más expectativa con respecto al gran evento escolar de este año promocionándolo con un cartel que llame la atención. Te resultará fácil hacer uno aunque creas que no tienes habilidades artísticas. Comienza explorando las plantillas de carteles para feria de ciencias. Elige la que creas que capturará mejor el tema de este año y luego personalízala.
Personalización Sencilla con Herramientas de Diseño
Escribe el nombre y los detalles importantes de tu feria con las herramientas de texto. No olvides agregar recordatorios para estudiantes y padres. Si quieres modificar las fuentes, desplázate entre más de un centenar de opciones que ofrece el editor. También puedes cambiar los colores usando la rueda de colores como guía.
Incorpora Elementos Visuales y Fondos Atractivos
Una vez que el texto esté listo, busca una imagen principal en la inmensa biblioteca multimedia. Puedes optar por una foto o una ilustración. Todas nuestras imágenes son obras de profesionales, pero puedes imprimirles tu propio estilo con nuestra herramienta de edición de fotos. Aplica un filtro dramático, mejora la imagen o aumenta la nitidez. ¿Crees que agregar un fondo hará que tu cartel parezca más interesante? Existen patrones, gradientes de colores, texturas y bordes que puedes arrastrar y soltar en el editor.
14 TRUCAZOS para DOMINAR CANVA y DEJAR PHOTOSHOP
tags: #credencial #feria #cientifica